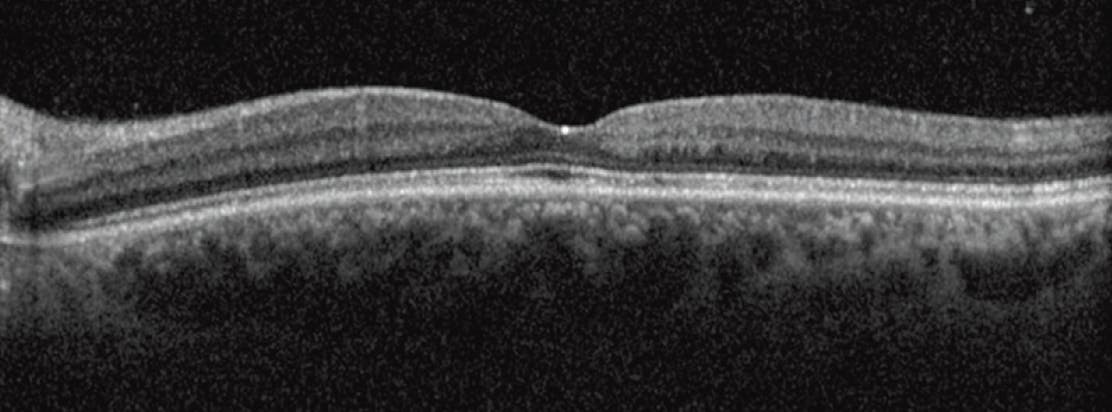

AT A GLANCE
- OCT often serves as the first diagnostic tool for suspected macular telangiectasia (MacTel) type 2 cases; a characteristic finding is temporal enlargement and widening of the foveal pit.
- OCT angiography may help visualize dilated perifoveal retinal vessels, particularly within the deep capillary plexus.
- Other modalities that can assist in diagnosing early-stage MacTel include confocal blue reflectance imaging, microperimetry, macular pigment optical density mapping, and multifocal electroretinography.
Macular telangiectasia type 2 (MacTel) is typically diagnosed late after patients experience progressive vision loss and may be misdiagnosed as more prevalent conditions such as diabetic macular edema.1 MacTel is primarily due to Müller cell neurodegeneration, leading to retinal thinning and subsequent vascular changes.2
With a novel treatment now available for patients with MacTel, clinicians must be prepared to diagnose these patients as early as possible. Here, we discuss imaging pearls when a patient presents with findings suspicious for MacTel.
THE INITIAL DIAGNOSIS
In the initial stages of MacTel, patients often present with mild or no visual symptoms, and BCVA may remain normal, even as the disease progresses. During disease progression, subtle signs may begin to manifest, such as blurred or distorted central vision, difficulty reading, loss of contrast sensitivity, or paracentral scotoma.3 A dilated fundus examination may reveal a normal retina in early states of the disease, but with progression, signs such as a dull or whitening foveal reflex, loss of retinal transparency, faint superficial retinal crystals, and telangiectatic vessels more pronounced temporally than nasally may become evident.4-6
OCT often serves as the first diagnostic imaging modality for suspected MacTel cases; a characteristic OCT finding is temporal enlargement and widening of the foveal pit, which leads to asymmetry and thinning on the temporal side of the fovea, resulting in an irregular foveal contour.6 Additional early signs detectable via OCT include disruptions in the external limiting membrane and ellipsoid zone (EZ), early alterations in the EZ/cone outer segment tips and photoreceptor outer segment reflectivity, hyperreflectivity of the inner retinal layers, superficial hyperreflective retinal dots, and focal outer lamellar defects at the fovea (Figure 1). As MacTel progresses, more pronounced changes can be observed, such as cavity formation, retinal thinning, pigment migration, internal limiting membrane drapes, development of a neovascular membrane, and eventual retinal atrophy.6-8

Figure 1. An OCT scan in early MacTel shows a widening of the foveal pit, inner retina layer hyperreflectivity, and minimal EZ/cone outer segment tips alteration.
Fundus autofluorescence (FAF) can be a valuable tool for revealing a mild loss of hyperautofluorescence in the fovea due to loss of lutein and zeaxanthin (Figure 2). However, light exposure during retinal examinations may cause bleaching of lutein and zeaxanthin in the unaffected retina, leading to a loss of contrast between the normal retina and MacTel lesions, potentially resulting in missed alterations. Therefore, clinicians should consider acquiring an FAF image after a 30-minute recovery.9
OCT angiography (OCTA) may help visualize dilated perifoveal retinal vessels, particularly within the deep capillary plexus. It highlights vessel distortion in the foveal avascular zone and the presence of branching vessels, which can be detected in the early stages of the disease.6 In early-stage MacTel, capillary density may remain normal or decrease in the superficial and deep capillary plexuses, confusing the condition with early diabetic retinopathy.10,11 Additionally, microcysts are sometimes observed in the ganglion cell and inner nuclear layers, corresponding to the small lacunae in both plexuses.10 However, in cases of diagnostic uncertainty, fluorescein angiography (FA) can reveal abnormal vessels on the temporal side, displaying early and late perifoveal hyperfluorescence (Figure 3).6,12

Figure 3. OCTA and FA in early MacTel exhibit faint vascular changes in the temporal side of the fovea and late-phase inferotemporal fluorescein leakage.
ADJUNCT IMAGING CONSIDERATIONS
Other diagnostic modalities that can assist in diagnosing early-stage MacTel, although not routinely used, include confocal blue reflectance (CBR) imaging, microperimetry, macular pigment optical density (MPOD) mapping, and multifocal electroretinography (mfERG).
CBR shows a well-defined, generally oval parafoveal area of increased reflectance, corresponding to the area of transparency loss. This area is slightly larger than the region of leakage observed in late-phase angiography. Clinicians should perform this imaging after dark adaptation, as the intensity tends to fade with continuous light exposure (Figure 4).13
Figure 4. CBR in MacTel shows decreased central hyporeflectance after dark adaptation, as observed immediately after FAF (A) and 30 minutes later (B).
Microperimetry often reveals functional scotomas correlated with areas of EZ loss rather than visual acuity loss. Although a valuable tool, it is subject to lower-session variability and relies on patient compliance.14 Additionally, MPOD mapping demonstrates decreased macular pigment levels centrally in early stages of MacTel.15
The changes in mfERG responses indicate inner retinal layer dysfunction due to abnormal Müller cell function and are correlated with visual acuity. This modality could be used to objectively assess macular function in MacTel.16-18
BE SUSPICIOUS
Early-stage diagnosis has become increasingly critical with the advent of MacTel therapy. It should be suspected in asymptomatic or minimally symptomatic patients with unexplained visual problems. Multimodal imaging facilitates early diagnosis. OCT identifies foveal pit widening, slight temporal foveal thinning, and subtle retinal layer alterations. Loss of hypoautofluorescence on FAF can detect subtle retinal changes. OCTA detects mild perifoveal vessel dilation, and FA effectively identifies vessel changes and leakage. Other modalities such as microperimetry, MPOD mapping, and CBR imaging hold significant potential for the early detection and follow-up of MacTel.
1. Macular telangiectasia (MacTel). Macular Society. Accessed March 11, 2025. www.macularsociety.org/macular-disease/macular-conditions/mac-tel
2. Venkatesh R, Mangla R, Handa A, et al. Vitreomacular interface abnormalities in type 2 macular telangiectasia (MacTel). Graefes Arch Clin Exp Ophthalmol. 2024;262(5):1455-1463.
3. Heeren TFC, Chew EY, Clemons T, et al. Macular telangiectasia type 2: visual acuity, disease end stage, and the MacTel area: MacTel Project Report Number 8. Ophthalmology. 2020;127(11):1539-1548.
4. Sallo FB, Leung I, Zeimer M, et al. Abnormal retinal reflectivity to short-wavelength light in type 2 idiopathic macular telangiectasia. Retina. 2018;38:S79-S88.
5. Pauleikhoff D, Pauleikhoff L, Chew EY. Imaging endpoints for clinical trials in MacTel type 2. Eye. 2022;36(2):284-293.
6. Venkatesh R, Reddy NG, Mishra P, et al. The preproliferative stage in type 2 macular telangiectasia (MacTel type 2). Graefes Arch Clin Exp Ophthalmol. 2022;260(1):121-132.
7. Mirescu AE, Balta F, Barac R, et al. High-resolution imaging in macular telangiectasia type 2: case series and literature review. Diagnostics. 2024;14(13):1351.
8. Chew EY, Peto T, Clemons TE, et al. Macular telangiectasia type 2: a classification system using multimodal imaging; MacTel Project Report Number 10. Ophthalmol Sci. 2023;3(2):100261.
9. Sharief S, Venkatesh R, Mangla R, Chhablani J. Timing of ocular examination and retinal imaging for the diagnosis of type 2 macular telangiectasia (MacTel). Euro J Ophthalmol. 2023;33(6):NP79-NP81.
10. Au S, Su C. Optical coherence tomography angiography for macular telangiectasia type 2. J Ophthalmol Adv Res. 2022;3(1):1-10.
11. Mastropasqua R, Toto L, Mastropasqua A, et al. Foveal avascular zone area and parafoveal vessel density measurements in different stages of diabetic retinopathy by optical coherence tomography angiography. Int J Ophthalmol. 2017;10(10):1545.
12. Solberg Y, Dysli C, Wolf S, Zinkernagel MS. Fluorescence lifetime patterns in macular telangiectasia type 2. Retina. 2020;40(1):99-108.
13. Venkatesh R, Pereira A, Bavaharan B, et al. Relevance of multicolor imaging in type 2 macular telangiectasia. J Curr Ophthalmol. 2020;32(4):375-380.
14. Schmitz-Valckenberg S, Ong EL, Rubin GS, et al. Structural and functional changes over time in MacTel patients. Retina. 2009;29(9):1314-1320.
15. Srinivasan R, Teussink MM, Sloan KR, Bharat RPK, Narayanan R, Raman R. Distribution of macular pigments in macular telangiectasia type 2 and correlation with optical coherence tomography characteristics and visual acuity. BMC Ophthalmol. 2022;22(1):264.
16. Okada M, Robson AG, Egan CA, et al. Electrophysiological characterization of macular telangiectasia type 2 and structure–function correlation. Retina. 2018;38:S33-S42.
17. Goel N, Kumari A, Kumar S, Mehta A. Multifocal electroretinography in patients with macular telangiectasia type 2. Documenta Ophthalmologica. 2020;141(1):15-21.
18. Ledolter AA, Ristl R, Palmowski‐Wolfe AM, et al. Macular telangiectasia type 2: multimodal assessment of retinal function and microstructure. Acta Ophthalmologica. 2022;100(6):e1240-e1252.






















